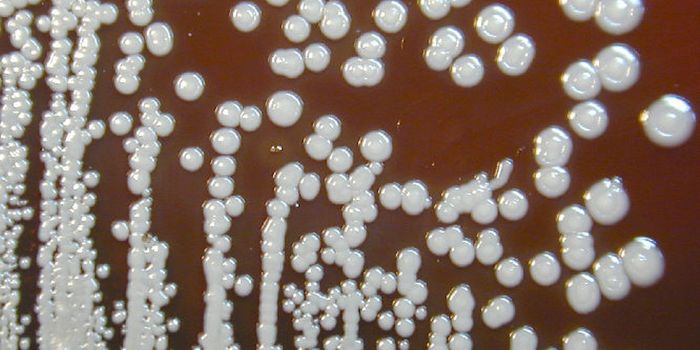
The CDC Investigates Several Cases of a Rare Tropical Disease

Cancer genetics and genomics
Cancer genetics and genomics is the study of how our genetic profiles are linked to the onset or progression of malignancies. Mutations leading to cancer can be inherited or acquired (also called somatic). Cancer genetics and genomic studies evaluate how such mutations relate to cancer. Additionally, genetic and genomic studies can determine how an individual will respond to therapy and may help determine the best course of treatment for cancer.
-
OCT 25, 2021Cell & Molecular BiologyLabroots virtual events are a great place to share research and learn about others work. These events feature participan ...Written By: Carmen LeitchOCT 22, 2021Genetics & GenomicsTo clear a viral infection, the human body has to mount an effective immune response. After detecting the pathogen, immu ...Written By: Carmen LeitchOCT 20, 2021Earth & The EnvironmentIt’s the time of year for all things pumpkin. But what do you really know about pumpkins? They are generally consi ...Written By: Samantha LottOCT 18, 2021Genetics & GenomicsFor decades, scientists have been trying to find ways to cure disorders that can be traced back to an error in one gene. ...Written By: Carmen LeitchOCT 10, 2021Cell & Molecular BiologyThere is a well-known causal connection between smoking and lung cancer, and most research on lung cancer has been focus ...Written By: Carmen LeitchOCT 05, 2021Genetics & GenomicsAs our body ages, cells have to divide to replenish those that become worn out or damaged. Most cells also carry the gen ...Written By: Carmen LeitchSEP 29, 2021Cell & Molecular BiologyCells carry the genome in their nucleus, and the genes that are expressed give a cell its identity. Researchers have bee ...Written By: Carmen LeitchSEP 22, 2021CancerThe human genome consists of genetic material known as DNA. We all have unique DNA sequences made up of four bases ...Written By: Katie KokolusSEP 18, 2021Genetics & GenomicsThe DNA in our cells can accumulate damage over may years. Environmental influences like UV light or cigarette smoke may ...Written By: Carmen LeitchSEP 13, 2021Genetics & GenomicsA genome contains instructions for making genes, and when an organism needs to produce proteins, it transcribes a gene s ...Written By: Carmen LeitchSEP 12, 2021Genetics & GenomicsSome diseases impact men, or women, at different rates or severities, with different symptoms or varied ages of onset; t ...Written By: Carmen LeitchSEP 11, 2021Genetics & GenomicsScientists sequenced most of the human genome abut two decades ago. It took many years to complete the project because o ...Written By: Carmen LeitchAUG 29, 2021Cell & Molecular BiologyThe loss of a microRNA might be interfering with neuromuscular synapse function, causing breathing muscle paralysis, sug ...Written By: Carmen LeitchAUG 24, 2021Clinical & Molecular DXFor patients diagnosed with metastatic breast cancer, it’s often not the primary tumor that has fatal consequences ...Written By: Tara FernandesAUG 18, 2021Cell & Molecular BiologyFor many years, researchers have studied how an enzyme called APOBEC3 can help protect the body from pathogenic viruses, ...Written By: Carmen LeitchAUG 10, 2021MicrobiologyThe bacterium Burkholderia pseudomallei is a pathogen that can live in water and soil, usually in tropical parts of nort ...Written By: Carmen LeitchAUG 01, 2021Genetics & GenomicsThroughout our lives, new cells often replace the ones that become damaged or worn out. As cells divide, they have to re ...Written By: Carmen LeitchJUL 26, 2021Genetics & GenomicsMany types of cells have to be replenished continuously throughout our lives, and the genome in the nucleus of those cel ...Written By: Carmen LeitchJUL 22, 2021Cell & Molecular BiologyTo study biology, researchers need models. Once those models might have been a bit limited to organisms like rats or mic ...Written By: Carmen LeitchJUL 21, 2021Cell & Molecular BiologyEven Giant Galapagos Tortoises, (seen here migrating in a photo by Juan Manuel García) are not safe from the world's ant ...Written By: Carmen LeitchJUL 08, 2021Genetics & GenomicsChildren with Down syndrome have a significantly higher likelihood myeloid leukemia occurring in the first five years of ...Written By: Carmen LeitchJUL 03, 2021Space & AstronomyNASA astronauts aboard the International Space Station (ISS) have developed and successfully carried out a CRISPR-Cas9 p ...Written By: Annie LennonJUN 30, 2021Genetics & GenomicsThe common, two-stranded helical structure of DNA was discovered over one hundred years ago. Many researchers would go o ...Written By: Carmen LeitchJUN 28, 2021Genetics & GenomicsWe carry two copies of each non-sex chromosome, and thus, two copies of most genes. For simplicity's sake, it's ...Written By: Carmen Leitch
OCT 25, 2021
Cell & Molecular Biology
Labroots virtual events are a great place to share research and learn about others work. These events feature participan
...
Written By:
Carmen Leitch
OCT 22, 2021
Genetics & Genomics
To clear a viral infection, the human body has to mount an effective immune response. After detecting the pathogen, immu
...
Written By:
Carmen Leitch
OCT 20, 2021
Earth & The Environment
It’s the time of year for all things pumpkin. But what do you really know about pumpkins? They are generally consi
...
Written By:
Samantha Lott
OCT 18, 2021
Genetics & Genomics
For decades, scientists have been trying to find ways to cure disorders that can be traced back to an error in one gene.
...
Written By:
Carmen Leitch
OCT 10, 2021
Cell & Molecular Biology
There is a well-known causal connection between smoking and lung cancer, and most research on lung cancer has been focus
...
Written By:
Carmen Leitch
OCT 05, 2021
Genetics & Genomics
As our body ages, cells have to divide to replenish those that become worn out or damaged. Most cells also carry the gen
...
Written By:
Carmen Leitch
SEP 29, 2021
Cell & Molecular Biology
Cells carry the genome in their nucleus, and the genes that are expressed give a cell its identity. Researchers have bee
...
Written By:
Carmen Leitch
SEP 22, 2021
Cancer
The human genome consists of genetic material known as DNA. We all have unique DNA sequences made up of four bases
...
Written By:
Katie Kokolus
SEP 18, 2021
Genetics & Genomics
The DNA in our cells can accumulate damage over may years. Environmental influences like UV light or cigarette smoke may
...
Written By:
Carmen Leitch
SEP 13, 2021
Genetics & Genomics
A genome contains instructions for making genes, and when an organism needs to produce proteins, it transcribes a gene s
...
Written By:
Carmen Leitch
SEP 12, 2021
Genetics & Genomics
Some diseases impact men, or women, at different rates or severities, with different symptoms or varied ages of onset; t
...
Written By:
Carmen Leitch
SEP 11, 2021
Genetics & Genomics
Scientists sequenced most of the human genome abut two decades ago. It took many years to complete the project because o
...
Written By:
Carmen Leitch
AUG 29, 2021
Cell & Molecular Biology
The loss of a microRNA might be interfering with neuromuscular synapse function, causing breathing muscle paralysis, sug
...
Written By:
Carmen Leitch
AUG 24, 2021
Clinical & Molecular DX
For patients diagnosed with metastatic breast cancer, it’s often not the primary tumor that has fatal consequences
...
Written By:
Tara Fernandes
AUG 18, 2021
Cell & Molecular Biology
For many years, researchers have studied how an enzyme called APOBEC3 can help protect the body from pathogenic viruses,
...
Written By:
Carmen Leitch
AUG 10, 2021
Microbiology
The bacterium Burkholderia pseudomallei is a pathogen that can live in water and soil, usually in tropical parts of nort
...
Written By:
Carmen Leitch
AUG 01, 2021
Genetics & Genomics
Throughout our lives, new cells often replace the ones that become damaged or worn out. As cells divide, they have to re
...
Written By:
Carmen Leitch
JUL 26, 2021
Genetics & Genomics
Many types of cells have to be replenished continuously throughout our lives, and the genome in the nucleus of those cel
...
Written By:
Carmen Leitch
JUL 22, 2021
Cell & Molecular Biology
To study biology, researchers need models. Once those models might have been a bit limited to organisms like rats or mic
...
Written By:
Carmen Leitch
JUL 21, 2021
Cell & Molecular Biology
Even Giant Galapagos Tortoises, (seen here migrating in a photo by Juan Manuel García) are not safe from the world's ant
...
Written By:
Carmen Leitch
JUL 08, 2021
Genetics & Genomics
Children with Down syndrome have a significantly higher likelihood myeloid leukemia occurring in the first five years of
...
Written By:
Carmen Leitch
JUL 03, 2021
Space & Astronomy
NASA astronauts aboard the International Space Station (ISS) have developed and successfully carried out a CRISPR-Cas9 p
...
Written By:
Annie Lennon
JUN 30, 2021
Genetics & Genomics
The common, two-stranded helical structure of DNA was discovered over one hundred years ago. Many researchers would go o
...
Written By:
Carmen Leitch
JUN 28, 2021
Genetics & Genomics
We carry two copies of each non-sex chromosome, and thus, two copies of most genes. For simplicity's sake, it's
...
Written By:
Carmen Leitch